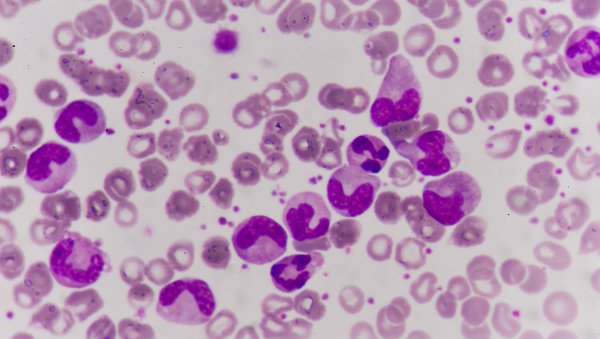
Czy wszyscy chorzy na ostrą białaczkę limfoblastyczną Ph(+) wymagają przeszczepienia allogenicznego krwiotwórczych komórek macierzystych?

Zgodnie z obecnym stanem wiedzy, oczywiście przy braku przeciwwskazań, WSZYSCY chorzy na ostrą białaczkę limfoblastyczną są kandydatami do wykonania u nich przeszczepienia allogenicznego komórek macierzystych krwiotworzenia. Ale czy na pewno wszyscy?
Materiał przeznaczony wyłącznie dla pracowników służby zdrowia
Ten materiał jest dostępny dla zarejestrowanych użytkowników.
Zaloguj się
Szanowni użytkownicy,
część materiałów udostępnianych na naszym portalu jest przeznaczona
wyłącznie dla lekarzy.
Wynika to z regulacji prawnych, do których musimy się stosować.
Jeśli nie jesteś lekarzem, zachęcamy do korzystania z przygotowanych przez nas materiałów dostępnych w zakładce dla pacjentów.







